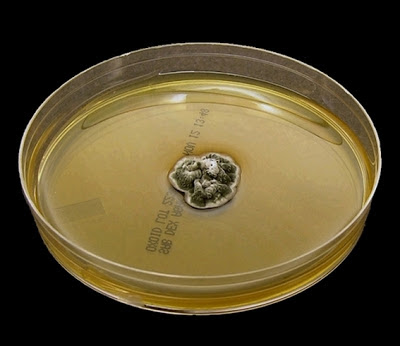

Unidentified Environmental Black Mould No.1
As the title of this Blog Site suggests, Microbiology should be Fun! The pursuit of knowledge should be as enjoyable as discovery - the journey as much fun as the destination…especially if one has yet to arrive.
Presented in this post is an environmental isolate whose identity has of yet eluded me. (No.1 as I'm sure I'll have more)As my resources are primarily medical, environmental fungi which have little or no medical importance are poorly, if at all documented. Regardless, one quick look at a hastily prepared adhesive-tape mount convinced me to have a closer look and to share a few photos. Perhaps a reader of this post might offer a clue or steer me in the right direction so as to give this dark, spiky fellow a proper name.
Ecology: As mentioned, this isolate was an environmental contaminant and its distribution and preferred habitat remains unknown.
Macroscopic Morphology: Colonies are slow growing, reaching one to two centimeters in diameter in 10 – 14 days at 30oC. Growth has yet to be tested at 37oC or 40 – 45oC. Growth starts off white but quickly develops a dark olivacious to smoky-grey to black appearance. A small white outer margin may remain. Overall texture is quite leathery yet surface is somewhat powdery. Reverse is rather unremarkable.
Unidentified Black Mould on SAB media after 10 days of growth at 30oC.
Microscopic Morphology: Hyphae are septate and quickly develop a dark pigmentation. Branches leave the main hyphae frequently, but not exclusively, at near right angles. The branches taper towards the apex where the tips appear pointed, giving an all-around `spiky `appearance. Hyphal branches geniculate (knee-like bends) where the oval or lemon shaped conidia (~3.5 X 4.5 µm) are produced. Smooth, single celled, conidia appear slightly blunter at the end of attachment.
Note: All photographs which appear below were taken from slide cultures using the Leica DMD-108 microscope.
Unidentified black mould (LPCB, X400)
(100 µm bar appears at top of photo for scale)
Unidentified black mould - the jungle! (LPCB, X400)
At 48 hours incubation the conidia are just forming.
Unidentified black mould - Note: branches often extend at near right-angles to the main hyphae. Very spiky appearance, particularly the hyphae near the micron bar at the upper right. (LPCB, X400+10)
Unidentified Black Mould - spiky, pointed appearance of hyphae, tapering towards the apex. Black pigmentation is developing while other hyphae are still hyaline and appear blue from the stain. Several conidia are visible. (LPCB, X400+10)
Unidentified Black Mould - Darkly pigmented hyphae appear to extend at various angles in this photo. Conidia extend from the branches along the branches.
(LPCB, X1000)
Unidentified Black Mould - pigmented hyphae with lemon or egg-shaped conidia in a less cluttered view from the one above. (LPCB, X1000)
Unidentified Black Mould - A closer look at the arrangement of conidia being produced along the hyphal branches. (LPCB, X1000+10)
Unidentified Black Mould - Pigmented septate hyphae with branching. Pigmented, smooth-walled, single celled conidia produced along the branches. (LPCB, X1000)
Unidentified Black Mould - Pigmented hyphae seen with extensive branching. At this magnification the geniculate (bent-knee) structure of the branches become obvious where the conidia are, or have been produced. The hyphal branch takes on a slight zig-zag appearance at this point. (LPCB, X1000+10)
Unidentified Black Mould - Ovoid, egg-shaped, lemon shaped? conidia are seen along the pigmented hyphal branches. Conidia are the youngest of the structures and therefore still appear blue from the stain. Septations are clearly visible and the hyphal branch in the center of the photo has the zig-zag appearance typical of geniculate (sympoidal?) growth.
(LPCB, X1000+10)
Unidentified Black Mould - One last look at many of the structures already noted, combined in one photo. (LPCB, X 1000)
Pathogenicity: As this isolate was not obtained from a clinical sample, its pathogenicity remains uncertain until it can be fully identified. Failure to find it in several medical mycology reference texts suggests that in may be an environmental saprobe with little clinical importance. Growth at 37oC remains to be tested and would determine if this fungus can grow at normal body temperature. These days most organisms might be considered to be `opportunistic` particularly with immunocompromised individuals.
* * *